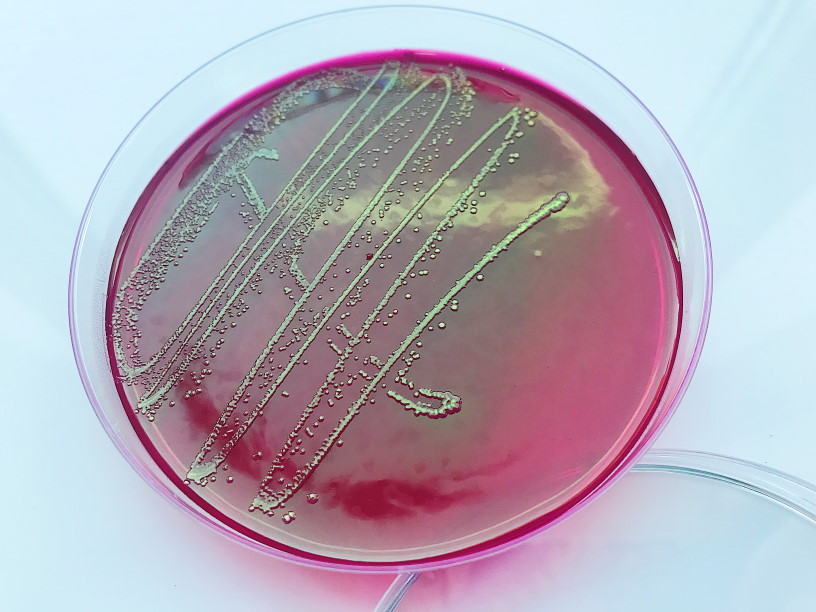

Промикробы: Пробуждение патогенной силы
Вот и настал черёд третьей и заключительной серии нашего увлекательного текстового сериала об инфекциях. Может показаться, что мы уже всё о них знаем, но нет, есть ещё микробы в микробовницах. Итак, бактериальный агент попал в свою большую жертву. Дальше начинаются основные этапы инфекционного процесса:
1. Адгезия — прикрепление микроорганизма к соответствующим клеткам хозяина.
2. Колонизация — закрепление микроорганизмов в соответствующем участке.
3. Размножение — увеличение количества захватчиков.
4. Пенетрация — проникновение в нижележащие слои и распространение незваных гостей.
5. Повреждение клеток и тканей — связано с размножением, пенетрацией и распространением инфекционного агента.
⠀
Есть ещё два важных термина, без которых нам не обойтись, — патогенность и вирулентность. Патогенность — потенциальная возможность вызывать при благоприятных условиях специфический инфекционный процесс. Это свойство характеризует видовые генетические особенности микроорганизмов, позволяющие преодолеть защитные механизмы хозяина, проявить свои патогенные свойства. По способности вызывать заболевания микроорганизмы можно разделить на патогенные, условно-патогенные и непатогенные. Про условно-патогенные я вам уже все уши прожужжала. Например, на фото — любимая всеми нами кишечная палочка, она условно-патогенный микроорганизм.
⠀
Вирулентность — это индивидуальное количественное выражение патогенности, степень способности данного инфекционного агента заражать данный организм. Очень много лабораторных мышей полегло на благо определения вирулентности. Вирулентность микроорганизмов, в свою очередь, тесно связана с токсигенностью и инвазивностью.
⠀
Токсигенность — это, что вполне логично, способность синтезировать токсины, которые отрицательно воздействуют на макроорганизм, изменяя его метаболические функции. Токсины можно разделить на две большие группы — экзотоксины и эндотоксины. Экзотоксины продуцируются во внешнюю среду, обычно они белковой природы, могут секретировать как грамположительными, так и грамотрицательными бактериями. Они очень токсичны, но легко разрушаются. Эндотоксины высвобождаются только при гибели бактерий, характерны для грамотрицательных бактерий, представляют собой сложные химические соединения клеточной стенки. Они менее токсичны, но тяжело разрушаются.
⠀
Инвазивность — способность микроорганизма преодолевать защитные барьеры организма, проникать в органы, ткани и полости, размножаться в них, подавлять защитные средства макроорганизма. Инвазионные свойства патогенных бактерий обеспечиваются за счет микробных ферментов, капсул и всяких специальных структур клетки. Капсула — вообще очень удобная вещь, если вы микроб, решивший колонизировать и подпортить кого-нибудь большого. Наличие капсул у бактерий затрудняет фагоцитоз — значит, иммунная система жертвы не страшна микрозлодею.
⠀
Чувствую, что я совсем запутала тебя, мой дорогой читатель. Прошу прощения за ушат терминов, выплеснутый под красивыми фотографиями. Но если вы их осилили и, может быть, даже что-то усвоили, то я самый счастливый микробиолог во всем макромире.